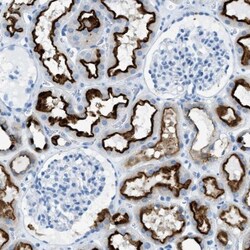
C21orf62 Antibody, Novus Biologicals 25 &mu;L; Unlabeled:Antibodies, Polyclonal

missing translation for 'onlineSavingsMsg'
Learn More
Learn More
C21orf62 Antibody, Novus Biologicals™
Rabbit Polyclonal Antibody
Brand: Novus Biologicals NBP1-88947-25ul
This item is not returnable.
View return policy
Description
C21orf62 Polyclonal specifically detects C21orf62 in Human samples. It is validated for Immunohistochemistry, Immunohistochemistry-Paraffin.
Specifications
| C21orf62 | |
| Polyclonal | |
| Immunohistochemistry, Immunohistochemistry-Paraffin 1:20 - 1:50 | |
| B37, B37PRED81, C21orf120, chromosome 21 open reading frame 120, chromosome 21 open reading frame 62, hypothetical protein LOC56245, PRED81 | |
| Rabbit | |
| Affinity Purified | |
| RUO | |
| 56245 | |
| Human | |
| IgG |
| Immunohistochemistry, Immunohistochemistry (Paraffin) | |
| Unconjugated | |
| PBS (pH 7.2) and 40% Glycerol with 0.02% Sodium Azide | |
| C21ORF62 | |
| This antibody was developed against Recombinant Protein corresponding to amino acids:TLVQDLKLSLCSTNTLPTEYLAICGLKRLRINMEAKHPFPEQSLLIHSGGDSDSREKPMWLHKGWQPCMYISFLD | |
| 25 μL | |
| Primary | |
| Specificity of antibody verified on a Protein Array containing target protein plus 383 other non-specific proteins. | |
| Store at 4C short term. Aliquot and store at -20C long term. Avoid freeze-thaw cycles. |
Product Content Correction
Your input is important to us. Please complete this form to provide feedback related to the content on this product.
Product Title
For Research Use Only
Spot an opportunity for improvement?Share a Content Correction